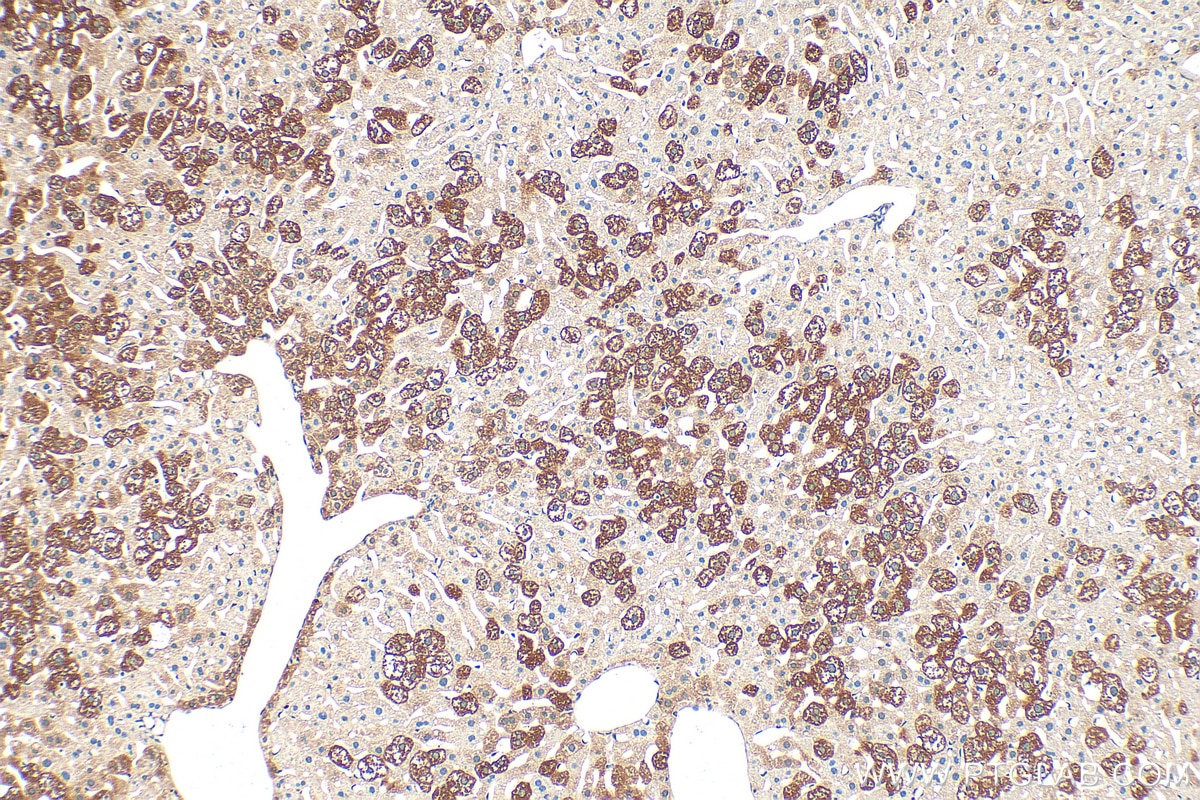
Immunohistochemical analysis of paraffin-embedded mouse liver tissue slide using 16688-1-AP (ATL2 antibody) at dilution of 1:200 (under 10x lens). Heat mediated antigen retrieval with Tris-EDTA buffer (pH 9.0). Immunohistochemistry (IHC) staining of mouse liver tissue using ATL2 Polyclonal antibody (16688-1-AP)
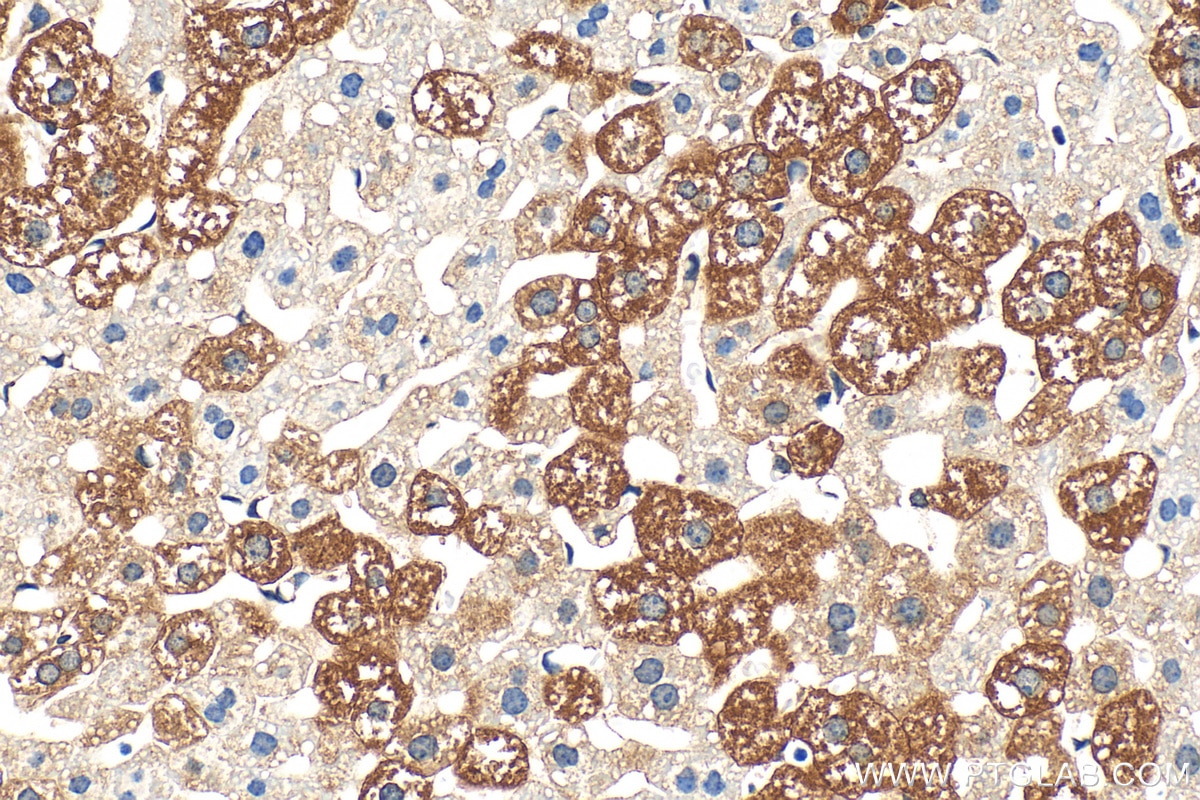
Immunohistochemical analysis of paraffin-embedded mouse liver tissue slide using 16688-1-AP (ATL2 antibody) at dilution of 1:200 (under 40x lens). Heat mediated antigen retrieval with Tris-EDTA buffer (pH 9.0). Immunohistochemistry (IHC) staining of mouse liver tissue using ATL2 Polyclonal antibody (16688-1-AP)
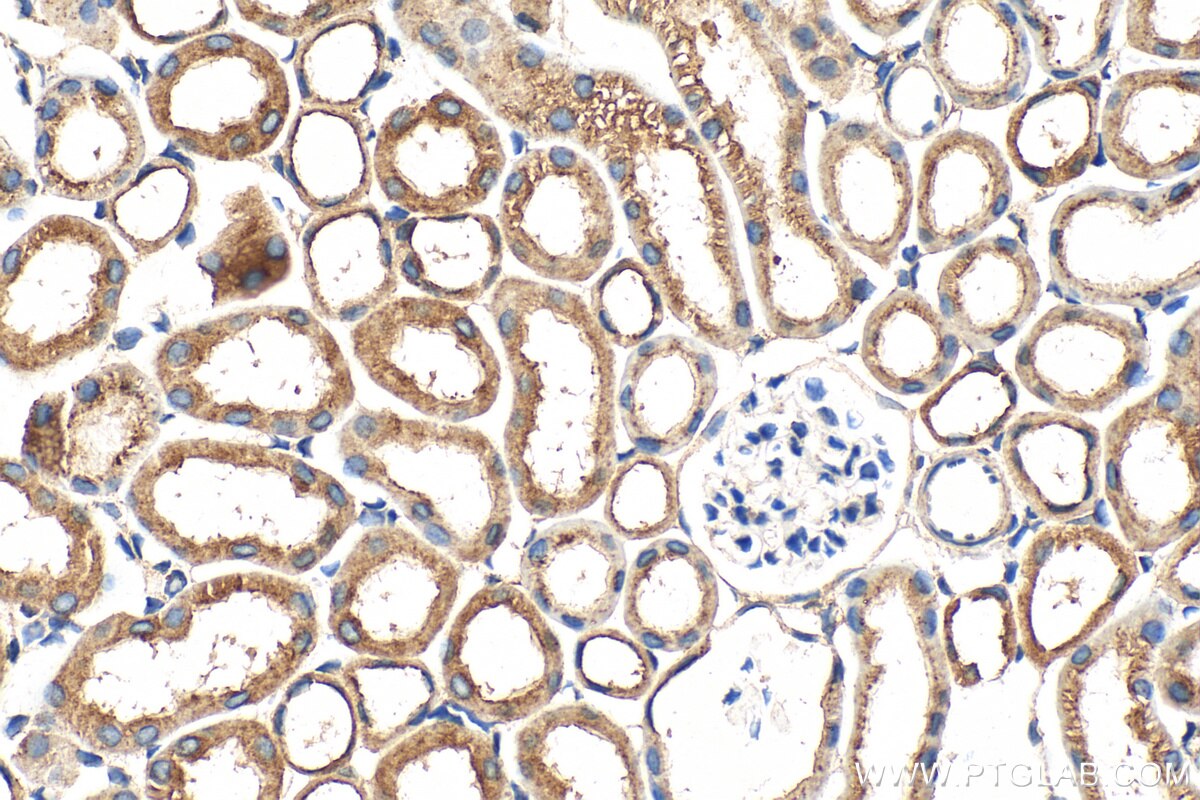
Immunohistochemical analysis of paraffin-embedded mouse kidney tissue slide using 16688-1-AP (ATL2 antibody) at dilution of 1:200 (under 40x lens). Heat mediated antigen retrieval with Tris-EDTA buffer (pH 9.0). Immunohistochemistry (IHC) staining of mouse kidney tissue using ATL2 Polyclonal antibody (16688-1-AP)

Tested Applications
| Positive WB detected in | HEK-293 cells, A549 cells, HeLa cells, Jurkat cells, HepG2 cells, SH-SY5Y cells |
| Positive IHC detected in | human intrahepatic cholangiocarcinoma tissue, human ovary cancer tissue, mouse kidney tissue, mouse liver tissue Note: suggested antigen retrieval with TE buffer pH 9.0; (*) Alternatively, antigen retrieval may be performed with citrate buffer pH 6.0 |
Recommended dilution
| Application | Dilution |
|---|---|
| Western Blot (WB) | WB : 1:500-1:3000 |
| Immunohistochemistry (IHC) | IHC : 1:50-1:500 |
| It is recommended that this reagent should be titrated in each testing system to obtain optimal results. | |
| Sample-dependent, Check data in validation data gallery. | |
Published Applications
| KD/KO | See 1 publications below |
| WB | See 6 publications below |
| IF | See 2 publications below |
Product Information
16688-1-AP targets ATL2 in WB, IHC, IF, ELISA applications and shows reactivity with human, mouse samples.
| Tested Reactivity | human, mouse |
| Cited Reactivity | human, mouse, monkey |
| Host / Isotype | Rabbit / IgG |
| Class | Polyclonal |
| Type | Antibody |
| Immunogen |
CatNo: Ag10030 Product name: Recombinant human ATL2 protein Source: e coli.-derived, PGEX-4T Tag: GST Domain: 1-313 aa of BC053508 Sequence: MDTQGAFDSQSTIKDCATVFALSTMTSSVQVYNLSQNIQEDDLQHLQLFTEYGRLAMEEIYQKPFQTLMFLIRDWSYPYEHSYGLEGGKQFLEKRLQVKQNQHEELQNVRKHIHNCFSNLGCFLLPHPGLKVATNPSFDGRLKDIDEDFKRELRNLVPLLLAPENLVEKEISGSKVTCRDLVEYFKAYIKIYQGEELPHPKSMLQATAEANNLAAVAGARDTYCKSMEQVCGGDKPYIAPSDLERKHLDLKEVAIKQFRSVKKMGGDEFCRRYQDQLEAEIEETYANFIKHNDGKNIFYAARTPATLFAVMFA Predict reactive species |
| Full Name | atlastin GTPase 2 |
| Calculated Molecular Weight | 412aa,47 kDa; 583aa,66 kDa |
| Observed Molecular Weight | 66 kDa |
| GenBank Accession Number | BC053508 |
| Gene Symbol | ATL2 |
| Gene ID (NCBI) | 64225 |
| RRID | AB_1850898 |
| Conjugate | Unconjugated |
| Form | Liquid |
| Purification Method | Antigen affinity purification |
| UNIPROT ID | Q8NHH9 |
| Storage Buffer | PBS with 0.02% sodium azide and 50% glycerol, pH 7.3. |
| Storage Conditions | Store at -20°C. Stable for one year after shipment. Aliquoting is unnecessary for -20oC storage. 20ul sizes contain 0.1% BSA. |
Background Information
ATL2, also known as Atlastin GTPase 2, is involved in various cellular processes, including the organization of the Golgi apparatus, the endoplasmic reticulum tubular network membrane organization, and protein homooligomerization. It is located in the endoplasmic reticulum tubular network membrane and is an integral component of the membrane. The ATL2 gene has multiple transcripts and isoforms, with 18 transcripts (splice variants), 297 orthologues, and 10 paralogues. ATL2 also plays a significant role in the immune response, particularly in plants. In Arabidopsis thaliana, the ATL2 gene is involved in the response to fungal pathogen infection. The expression of ATL2 is low under normal growth conditions but is rapidly and significantly induced by exogenous chitin.also plays
Protocols
| Product Specific Protocols | |
|---|---|
| IHC protocol for ATL2 antibody 16688-1-AP | Download protocol |
| WB protocol for ATL2 antibody 16688-1-AP | Download protocol |
| Standard Protocols | |
|---|---|
| Click here to view our Standard Protocols |
Publications
| Species | Application | Title |
|---|---|---|
Nat Struct Mol Biol Aurora kinase A-mediated phosphorylation triggers structural alteration of Rab1A to enhance ER complexity during mitosis | ||
J Cell Biol Atlastin 2/3 regulate ER targeting of the ULK1 complex to initiate autophagy. | ||
Curr Biol ATL3 Is a Tubular ER-Phagy Receptor for GABARAP-Mediated Selective Autophagy.
| ||
NPJ Parkinsons Dis Deficiency of Perry syndrome-associated p150Glued in midbrain dopaminergic neurons leads to progressive neurodegeneration and endoplasmic reticulum abnormalities | ||